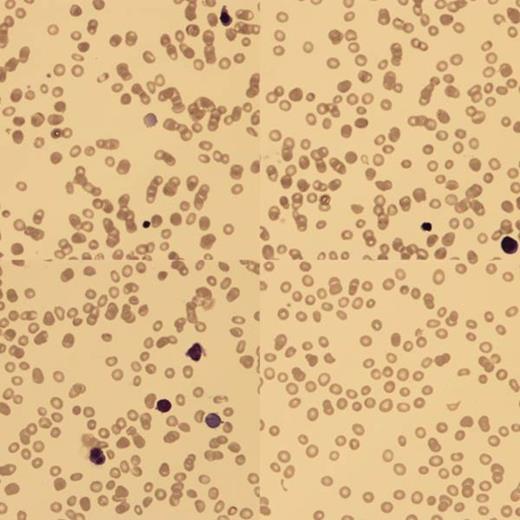
Fig 1:. BF showed poikilocytes, teardrops, macrocytes and NRBC with binucleate forms.

Abstract
A 3 months old (corrected age 1 month) ex–premature girl, born at 32/40 weeks by elective caesarean section was referred for investigation of anemia and liver failure, diagnosed antenatally. Her parents were first cousins. Their first daughter died within 24 hours from birth with anemia. Their second daughter was healthy.
At birth, blood analysis showed Hb 4g/dl, hepatitis with conjugated hyperbilirunemia (ALT 138, AST 1603, ALP 690 and bilirubin 324). Blood film (BF) confirmed a low reticulocyte count (RETC) and nucleated red blood cells (NRBC). There was no fragmentation and the Coomb's test was negative. An ultrasound scan showed smooth hepatomegaly. Upon transfer to us, she continued to have conjugated hyperbilirubinemia and low RETC.
BF showed poikilocytes, teardrops, macrocytes and NRBC with binucleate forms.
There were some immature lymphoid and monocytoid cells but peripheral immunophenotyping (IP) was normal. Parvovirus PCR was negative and there was no haematinic deficiency (Vitamin B12, folate, methylmalonic acid, homocysteine, transcobalamin). Sequencing of the G6PD and pyruvate kinase deficiency genes was normal. EMA dye binding, hemoglobin electrophoresis and genotyping were normal. Causes of failure to thrive and conjugated hyperbilirunaemia (screen for inborn errors of metabolism, α-1 Antitrypsin deficiency, TORCH infection, cystic fibrosis) were excluded.
Liver biopsy showed inflammation and extramedullary haemopoiesis.
The bone marrow aspirate was hypercellular with erythroid hyperplasia, dyserythropoiesis and no ring sideroblasts.
The bone marrow aspirate was hypercellular with erythroid hyperplasia, dyserythropoiesis and no ring sideroblasts.
IP excluded a clonal lymphocytic population and excess of blasts. Electron microscopy did not suggest congenital dyserythropoietic anemia (CDAs). Next generation sequencing showed no causative mutations for Diamond Blackfan anemia, Sideroblastic anemia, Dyskeratosis congenita, CDAs, Shwachman-Diamond and Pearson syndromes.
She was started on regular blood transfusions to keep her Hb>10g/dl and did not respond to high-dose B12 and folinic acid replacement. The LFTS normalized within 2 months. She was discharged home after 6 months in hospital. She still has splenomegaly, low RETC, is transfusion dependent, with developmental delay and growing at <0.4 centime
Whole exome sequencing (WES) was performed on the girl and her parents, and showed that she was homozygous for a severe, novel mutation in the SPTA-1 gene, coding for alpha spectrin, with no other candidate mutations found.
Discussion
Assuming autosomal recessive inheritance, WES identified 54 novel candidate mutations which predicted to be severe in the homozygous state. Of them, only one was expressed in red cells and likely to explain the phenotype. This mutation on the SPTA1 gene, not previously described in humans (exon 5, aa 2378), introduces a premature stop codon in the sequence encoding for the carboxy (C) terminal of the EF domain of á spectrin. This results in the loss of 41 amino acids from the C terminal.
The known mutations on the SPTA1 gene can cause hereditary elliptocytosis (HE), hereditary spherocytosis (HS) and also hereditary pyropoikilocytosis (HPP). Most of these are missense mutations in exon 2 of the SPTA gene, and impair the formation of the spectrin á2â2 heterotetramers. In HPP an additional mutation is thought to be necessary, resulting in partial spectrin deficiency (Swierczek et al 2013). Mutations have not previously been described in the EF-domain of alpha spectrin in humans.
However, Korsgren et al 2010, demonstrated that the sphIJ/sphIJ mouse with severe HS makes a mutant spectrin that lacks the last 13 amino acids of the EF domain. According to their proposed protein model, based on α-ankyrin, the EF domain amplifies the function of the α-spectrin actin binding domain in forming the spectrin-actin-4.1R complex. The loss of the 13 EF domain amino acids does not affect heterodimer assembly, but reduces F-actin binding. The mutation we identified causes deletion of the last 45 EF domain amino acids, resulting in the very severe phenotype in this family. We suggest that the red cells are too fragile to be released from the marrow, resulting in the phenotype of ineffective erythropoiesis (low reticulocytes) rather than haemolytic anemia typically associated with alpha spectrin mutations. We are currently undertaking proteomic studies to look for the presence of the truncated alpha spectrin protein in red cell membranes.
No relevant conflicts of interest to declare.
Author notes
Asterisk with author names denotes non-ASH members.